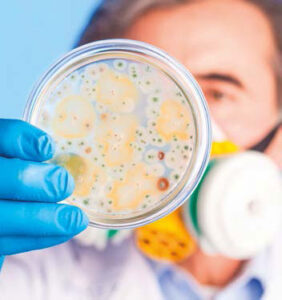
Il rapporto tra uomo e natura - Rivista Consumatori

Uno zoologo ci aiuta a inquadrare in una prospettiva ecologica la vicenda del coronavirus. Più che dare la colpa ai pipistrelli (che sono invece innocenti) o al pangolino, siamo noi che dobbiamo interrogarci sugli effetti delle nostre azioni che alterano gli equilibri ambientali.
L’emergenza COVID-19, con le sue terribili conseguenze sulla salute dell’uomo, ci ha fatto riflettere sul nostro ruolo di specie dominante e sul futuro di questo pianeta. Stiamo uscendo dall’illusione di essere invincibili attori del nostro destino, ci ha aperto gli occhi sulla stretta dipendenza dal buon funzionamento di meccanismi naturali ben più antichi di noi. Meccanismi che la nostra civiltà da tempo, troppo, ha iniziato a smantellare.
Cerchiamo allora di inquadrare il problema da un punto di vista più ampio: quello ecologico. Per aiutarci a chiarire ciò che sta succedendo, abbiamo intervistato Paolo Agnelli, zoologo del Museo di Storia Naturale di Firenze.
Che cosa sono i virus?
Che cosa sono i virus?
È difficile definirli. Non sono nemmeno cellule, ma qualcosa di ancora più semplice: sono formati soltanto da un involucro proteico e acidi nucleici. Microrganismi antichissimi in circolazione da più di tre miliardi di anni. Giusto per avere un termine di paragone: la nostra specie è arrivata appena 200mila anni fa. Una delle loro caratteristiche più insolite è che non sono in grado di riprodursi autonomamente e per farlo hanno bisogno delle cellule di un ospite. Le teorie darwiniane dell’evoluzione, che regolano la vita sulla Terra, valgono anche per i virus. Fin dalla loro comparsa si sono via via specializzati per riprodursi e sopravvivere all’interno di altre forme viventi, diversificandosi in un numero impressionante di tipologie differenti. Ogni forma virale finisce col vivere in equilibrio con il proprio ospite che con il tempo sviluppa un’immunità adattativa. Ciò significa che l’ospite sopravvive a questa sorta di “parassitismo” e il virus può prosperare.
Come passa il virus da una specie all’altra?
L’evento che può scombinare questo equilibrio è il cosiddetto spillover, il “salto di specie”. Avviene in seguito a una rara mutazione casuale che cambia qualcosa nel virus e se la mutazione è favorevole e ci sono in quel momento le condizioni adatte, come la vicinanza a un’altra specie, ecco che il nuovo virus prova a espandersi nel nuovo ospite. Quando la nuova specie ospite è l’uomo, nella maggior parte dei casi il virus si rivela innocuo, ma talora provoca patologie più o meno gravi, dal raffreddore all’HIV. La nostra facilità di spostarci da un continente all’altro, di trasportare merce, in poco tempo favorisce la trasmissione di quel virus da un uomo all’altro e l’espandersi dell’area geografica coinvolta.
Abbiamo delle responsabilità?
Molte. Invadiamo habitat naturali e territori vergini, deforestiamo, inquiniamo, cacciamo in maniera indiscriminata, provochiamo cambiamenti climatici… in definitiva alteriamo gli equilibri naturali e modifichiamo anche i comportamenti delle altre specie, aumentando così le probabilità di entrare in stretto contatto con loro. Quello che è avvenuto nel mercato di Wuhan ne è un esempio estremo. La compresenza, in un unico luogo, dei più diversi animali selvatici, vivi o appena macellati, in pessime condizioni igieniche, a diretto contatto con le persone e addirittura consumati come cibo, ha aumentato enormemente le probabilità di questo salto di specie.
Qual è l’animale che ci ha passato il virus?
Nel caso del COVID-19 è ormai certo che il virus sia arrivato dal pangolino, in altri casi erano stati la civetta delle palme (SARS), il maiale (A/H1N1) e il cammello (MERS) a “contagiare” i primi umani da cui è partita l’infezione. Studi recenti stanno rivelando che il COVID-19 è geneticamente vicino a quello che vive in una specie di pipistrello cinese, ma non è lo stesso. Probabilmente in tempi più o meno remoti questo virus è passato al pangolino e dal pangolino all’uomo, con modalità ancora poco chiare, ma verosimilmente perché utilizzato a scopo alimentare.
Dobbiamo aver paura dei nostri pipistrelli?
No, il passaggio diretto di un virus dai pipistrelli all’uomo è un evento rarissimo, anche perché le nostre possibilità di contatto diretto con un pipistrello o con le sue feci sono davvero scarse e non ci sogneremmo mai di cibarcene! In Europa si sono registrati alcuni rari casi di passaggio del virus della rabbia da alcuni pipistrelli all’uomo, ma soltanto in seguito a catture a scopo scientifico dato che, anche se malato, un pipistrello non diventa mai aggressivo.
In Europa si sono registrati alcuni rari casi di passaggio del virus della rabbia da alcuni pipistrelli all’uomo, ma soltanto in seguito a catture a scopo scientifico dato che, anche se malato, un pipistrello non diventa mai aggressivo.
Bisogna poi considerare che sulla Terra vivono più di 1.400 specie di pipistrelli. Quindi dobbiamo distinguere. Non ha alcun senso temere “il pipistrelloì” in generale. Ogni specie è molto diversa dalle altre e ognuna ha i suoi virus. Quelle autoctone sono molto diverse da quelle cinesi, distanti migliaia di chilometri: facendo un paragone sarebbe come aver paura di essere sbranati dal gatto del vicino solo perché è uno stretto parente della tigre che vive in Asia. Ricordiamo che in caso di una pandemia come quella attuale, l’unico untore da temere è l’uomo. Perché una volta verificatosi il raro evento di spillover, da un animale selvatico verso la nostra specie, la probabilità che si ripeta in un altro luogo del pianeta è quasi la stessa di venire colpiti da un meteorite! I pipistrelli non sono untori, sono anzi una risorsa importante.
Pensiamo al loro ruolo di predatori di insetti dannosi all’agricoltura o alla salute. Riuscire poi a capire come riescano a essere particolarmente resistenti ai virus è importantissimo in campo medico. Questi meccanismi sembrano anche responsabili della loro incredibile longevità, che può raggiungere addirittura il record di quarant’anni contro i due di un comune toporagno che ha le stesse dimensioni. Diamo fiducia allora alla ricerca scientifica, l’unica che può darci risposte utili e affidabili.
In questa circostanza, in cui le informazioni sono spesso confuse e approssimative, è importante più che mai far circolare notizie corrette.
Esattamente. Vi racconto un episodio significativo che ha molto allarmato noi ricercatori. Una ditta di disinfestazione, che si vanta di operare nel settore dal 1937, appena scoppiata la pandemia ha promosso tra i vari servizi uno dedicato allo sterminio dei pipistrelli, secondo loro «probabili portatori del coronavirus». La pubblicità è stata rimossa dopo che alcuni scienziati e l’Ispra (Istituto superiore per la protezione e la ricerca ambientale) hanno ricordato che «i pipistrelli italiani e i loro rifugi sono strettamente tutelati dalla legge del nostro Paese e dalle norme comunitarie, che ne vietano, tra l’altro, l’uccisione, l’alterazione o la distruzione dei siti in cui essi sostano, si riproducono o svernano». Proprio perché, prosegue la nota dell’Istituto, «i pipistrelli italiani svolgono un importantissimo servizio ecosistemico, sopprimendo insetti effettivamente o potenzialmente nocivi alla salute umana, alle aree coltivate e ai boschi. Pertanto, la presenza di pipistrelli, anche in prossimità di aree abitate, costituisce un elemento positivo e non deve causare preoccupazione. L’Italia si è impegnata sul piano internazionale nella tutela di questi animali, minacciati dalla scomparsa o dall’alterazione dei loro habitat così come dallo sviluppo di infrastrutture e diffusione di pesticidi, aderendo alla convenzione Unep (United nations environment program) denominata EUROBATS con legge n. 104 del 2005». Una leggerezza, se così vogliamo chiamarla, che rischia di compromettere anni di corretta informazione e sensibilizzazione.
Dobbiamo dunque guardare a questi animali con interesse ed evitare conclusioni superficiali, che potrebbero destare sciocche paure e compromettere la sopravvivenza di questi straordinari animali, mettendo in crisi, ancora di più, i nostri ecosistemi terrestri, così già duramente provati e saccheggiati, e di conseguenza la nostra salute.
Articolo di Silvia Amodio pubblicato sulla rivista Consumatori – edizione Lombardia di maggio 2020.
Rassegna stampa





